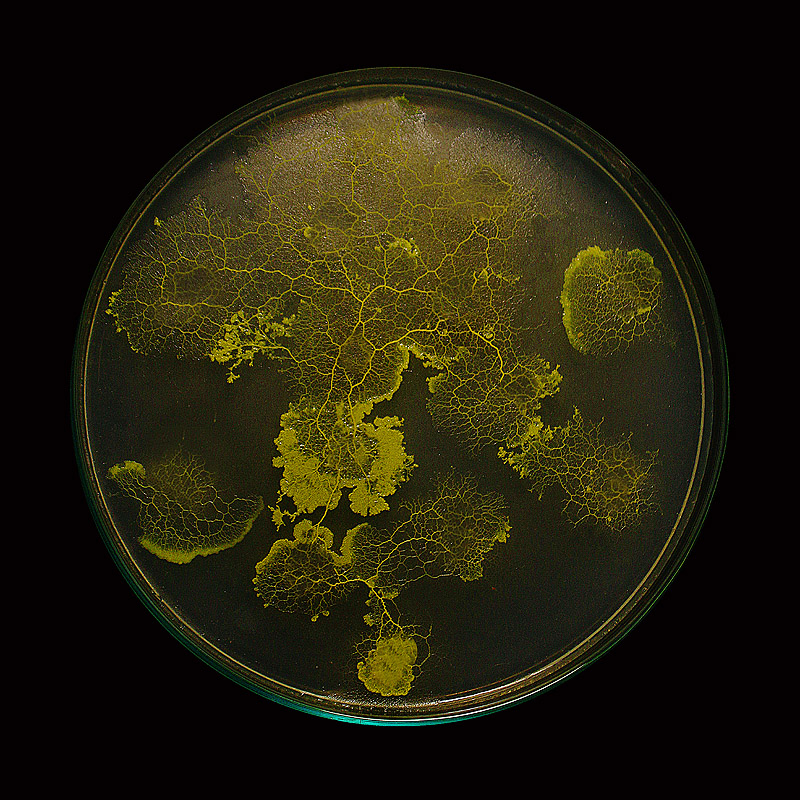

Del 23 de febrero al 25 de abril tiene lugar la quinta edición del programa “Mutations/Creations” dedicado a la relación entre el arte y el mundo de las redes desde los años 40 hasta la actualidad.
Con la exposiciĂłn Mundos de redes—RĂ©seaux-mondes, el Centro Pompidou se transforma en un laboratorio de creaciĂłn e innovaciĂłn, en la frontera entre las artes, la ciencia y la ingenierĂa, en la que más de 60 artistas, arquitectos y diseñadores cuestionan el lugar de las redes en nuestras sociedades. Más que nunca, en la era de internet, la red está en el centro del cambio tecnolĂłgico y de asuntos sociales como la vigilancia, la atomizaciĂłn del individuo y la red de las cosas vivas.
Imagen superior: Jenna Sutela.
La exposición, comisariada por Marie-Ange Brayer y Oliver Zeitoun, muestra más de100 obras desde 1940 hasta la actualidad, entre las que se incluyen algunas especialmente diseñadas para la ocasión y otras que reactivan redes perdidas, como el dispositivo “Minitel”. Obras conectadas a la web en tiempo real, redes de criptomonedas, plataformas de media social y entre ellas, un proyecto español; The Wrong Biennale, que proyectará, de forma continuada, 10 horas de videos de mas de 70 artistas.
EcoLogic Studio.
EcoLogic Studio.
La exposiciĂłn comienza con las utopĂas arquitectĂłnicas del periodo de postguerra. La nociĂłn de “red global” se localizaba entonces en prácticas artĂsticas en torno a la cibernĂ©tica, justo en un momento en el que la sociedad de la informaciĂłn emergĂa. En los años 80, la red del ordenador se convertĂa en un medio artĂstico con el arte telemático y el Net.art. Diez años despuĂ©s, las prácticas artĂsticas evolucionan en una red con una dimensiĂłn polĂtica y ubicua.
Tras la emancipatoria utopĂa de las redes, los artistas cuestionan de forma crĂtica sus efectos unidos a la vigilancia de la sociedad, la omnipresencia de las redes sociales y la apariciĂłn de los blockchains, en una invisible, incluso oculta dimensiĂłn de la red.
Un retorno a la etimologĂa inicial de la palabra “red” se llevará a cabo, explicando el papel de esta red en el arte, el diseño y la arquitectura. Finalmente, la primera red es la caracterizada por la auto-organizaciĂłn. Enfrentada a la crisis medioambiental, la historia entrelazada de las cosas vivas se abre a nuevas ecologĂas artĂsticas y post-antropogĂ©nicas, que integran principios de interdependencia y continuidad entre las formas de las cosas vivas.
La exposición está integrada por cuatro bloques que abordan diferentes épocas y distintos enfoques de las redes en relación con el arte:
1- Red global—Réseau global
El primero, Red global—RĂ©seau global , hace un recorrido por las primeras expresiones artĂsticas de una red global que surgieron en los años 1950 con artistas como Constant y el arquitecto-ingeniero Richard Buckminster Fuller. Los artistas adoptaban el mundo conectado de la cibernĂ©tica, el procesamiento automático de datos y las redes como sistema de organizaciĂłn general. Nicolas Schöffer se convirtiĂł en el principal representante del arte cinĂ©tico además de percusor del arte electrĂłnico y digital.
 Constant.
Constant.
Ya en 1948 teorizĂł sobre el espaciodinamismo, el cual definiĂł como “la integraciĂłn dinámica del espacio en la obra plástica”, en la intersecciĂłn del arte y la tecnologĂa. En 1959, Constant, fundador del grupo CoBrA, apartĂł la pintura para dedicarse por completo a New Babylon, el primer proyecto utĂłpico por una ciudad global, interconectada y en constante desarrollo. Con Spatiovore, Constant genera un espacio arquitectĂłnico genĂ©rico, destinado a recibir migrantes en el curso de sus viajes por la tierra.
 Nicolas Schöffer.
Nicolas Schöffer.
En 1969, Allan Kaprow creĂł Hello, una de las primeras obras interactivas que funcionaban como una red, con conexiones tanto virtuales como fĂsicas. En los 80, las redes informáticas se convirtieron en un medio artĂstico. En la era del arte telemático y las redes de telecomunicaciones de todo el planeta, los datos de informaciĂłn constituyen el tema mismo del trabajo.
2- CrĂtica de las redes— Critique des rĂ©seaux
Bajo el tĂtulo CrĂtica de las redes— Critique des rĂ©seaux, el segundo bloque presentan a artistas del Net.Art como JODY o Heath Bunting, como los primeros en cuestionar la dimensiĂłn polĂtica y estĂ©tica de Internet de una forma crĂtica y pirática. A partir de ahĂ, elaboraron un arte en red derivado de los movimientos de los hackers y sostenido por prácticas colaborativas de programaciĂłn de cĂłdigo abierto.
 Mika Tajima.
Mika Tajima.
Mientras que los individuos son totalmente dependientes de las plataformas tecnológicas, las nuevas infraestructuras de control observan sus cuerpos y sus vidas privadas, llegando incluso a predecir estados emocionales colectivos, rastreando meticulosamente los sentimientos expresados ​​en las redes sociales, tal y como muestra el trabajo de Mika Tajima, Human Synth.
 Simon Denny.
Simon Denny.
Las redes sociales están en el centro de los problemas actuales, y la tecnologĂa blockchain y los intercambios de datos han generado un mundo multiusuario que plantea la cuestiĂłn de la autorĂa y el carácter Ăşnico de una obra. Las sátiras sociales y polĂticas, como las de los artistas Simon Denny y NeĂŻl Beloufa, son tambiĂ©n la crĂtica a una red vertical totalizadora con una dimensiĂłn adictiva y depresiva, muy alejada de la utopĂa emancipadora de la red en los inicios de la era digital.
 Neil Beloufa.
Neil Beloufa.
3- Nudos y reticulaciones —Noeuds et reticulations
Nudos y reticulaciones —Noeuds et reticulations, plantea la nociĂłn de retĂculo, “lo que une” de Diderot, aparecida en el relato Le RĂŞve de D’Alembert para mostrar la visiĂłn sobre el origen textil de la arquitectura expuesta por arquitecto/historiador Gottfried Semper.
 Richard Vijgen.
Richard Vijgen.
Los nudos no sĂłlo son recurrentes en la filosofĂa, la historia de las ideas, las religiones, las matemáticas y el urbanismo, sino que tambiĂ©n “conectan” la historia del arte con el diseño y la arquitectura. En esta secciĂłn se presentan varios trabajos basados ​​en materiales textiles, explorando las metamorfosis de los nudos y los enredos, con obras de Robert Smithson, Sheila Hicks, Alan Saret, Richard Vijgen y Julien PrĂ©vieux.
 Julien Previeux.
Julien Previeux.
4- La red viva—Le réseau du vivant
Por Ăşltimo, en La red viva—Le rĂ©seau du vivant, se analiza como la viralidad digital se combina con la creciente consciencia de nuestras interacciones con lo no-humano, nuestra convivencia “en red” con otras especies en medio de una diversidad infinita de ecosistemas. Una nueva ecologĂa artĂstica integra este principio de la interdependencia y continuidad de todas las formas de vida, conectadas entre sĂ, como en Flylight de Studio Drift.
 Studio Drift.
Studio Drift.
TambiĂ©n muestra como una obra puede tomar la forma de una investigaciĂłn multidisciplinar, como ocurre en Cambio de los diseñadores Formafantasma, en la que el análisis transversal histĂłrico, polĂtico, econĂłmico y social de las actividades humanas revela la interconexiĂłn entre todas las redes de producciĂłn y conocimiento.
 Formafantasma.
Formafantasma.
Las tecnologĂas se exploran como herramientas de comunicaciĂłn entre especies, aspirando a conectarse con mundos en los lĂmites de la percepciĂłn humana. Los artistas y arquitectos exploran las especificidades de Physarum polycephalum, un organismo unicelular “inteligente”, para implementar nuevos protocolos de comunicaciĂłn y acciĂłn basados ​​en la inteligencia artificial y la biologĂa. En el corazĂłn de este pensamiento ecolĂłgico, la red se ha convertido en una malla, en palabras de Timothy Morton, en un vector de “la interconexiĂłn de todos los seres vivos y no vivos”.


